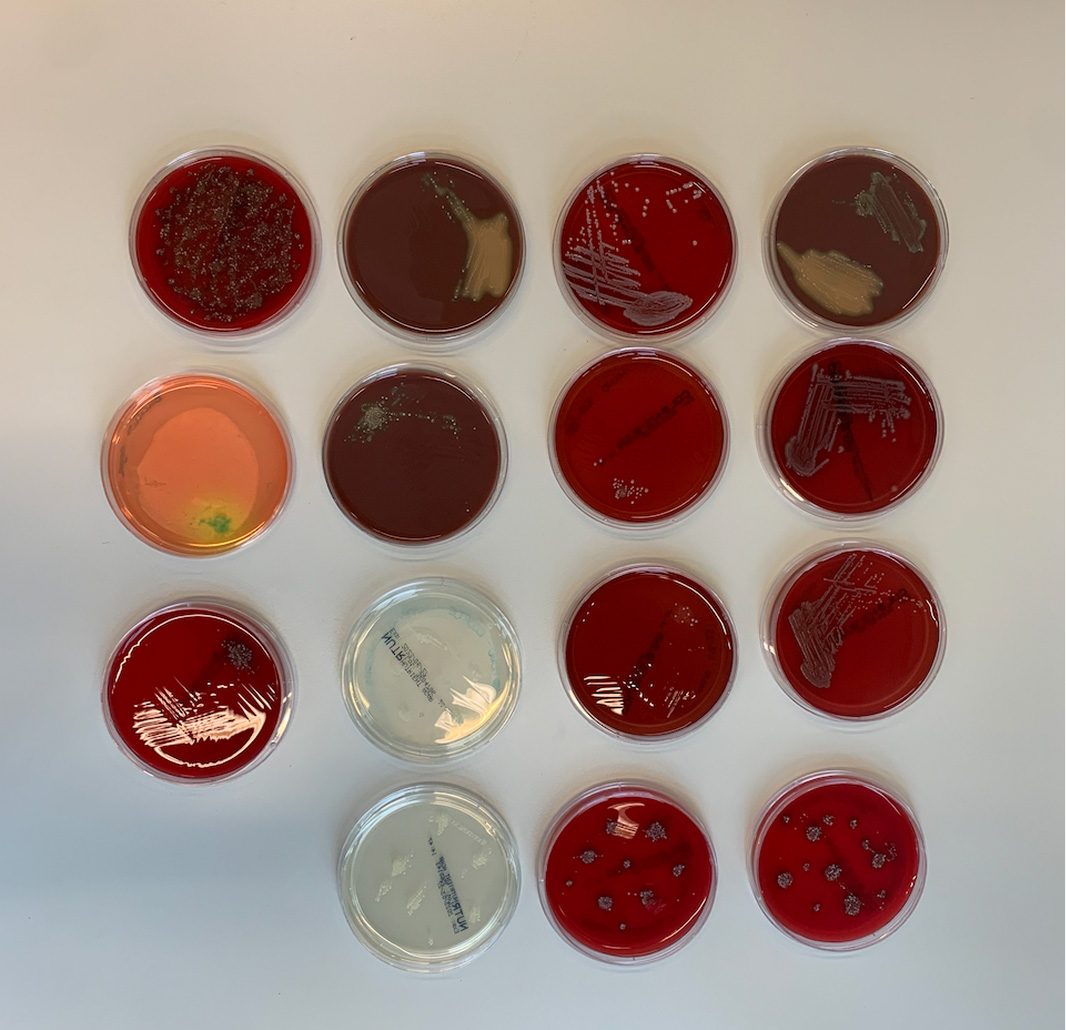
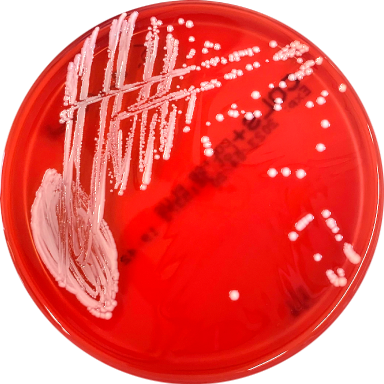

Homo Fermentis
A speculative scenario is developed, envisioning a world where personalized beer could be crafted using the microflora from an individual’s sweat and spittle.
The future of our food is uncertain. Several studies show that the way our current food system is organized is no longer sustainable. We must therefore work toward new, sustainable alternatives. This research, undertaken for the Department of Robotics and Sensor Technology at Avans, examined alternative relationships between humans and technological as well as natural actors in the food system through speculative design.

Biodiversity consists of all the life that makes up our natural world. It includes all species of plants, animals and microorganisms, which together form a ecosystem and maintain balance in nature and the food chain. However, our food production system as currently structured runs into numerous challenges. Human exploitation of nature for food production has far-reaching consequences for global biodiversity. Beyond creating climate problems, this exploitation threatens our food security as well.
But what if, instead of sourcing our food from distant places with all its negative impacts, we focus on finding food in the most local place possible: our own bodies? This research explores how human microbes may serve as part of the future of our food system.
The human body consists of an estimated 100 billion microorganisms, collectively known as the microbiome. Of these, approximately 1.5 trillion microbes live on the skin. One such bacterium, Lactobacillus, is not only a natural inhabitant of the skin but is also widely used in fermentation processes for food. Given it’s presence on the skin, could we potentially isolate this bacterium from our skin and use it in processes such a beer brewing?
In collaboration with the laboratory, I conducted several experiments, cultivating bacteria from saliva and sweat. Through these experiments, methods for isolating bacteria from a culture were explored. By combining theoretical insights with experimental results, I developed a strong rationale for the feasibility of the product.

A speculative scenario is developed, envisioning a world where personalized beer could be crafted using the microflora from an individual’s sweat and spittle.




We live in a world where people’s values and standards can have profound effects on our future, speculative design acts as a means of questioning these standards. It is transgressive, taking us out of our comfort zone, expanding the boundaries of how we view certain objects. This work therefore does not serve as a solution to the global food shortage, but rather invites us to resconsider ways we can look at our own bodies and their microbes.